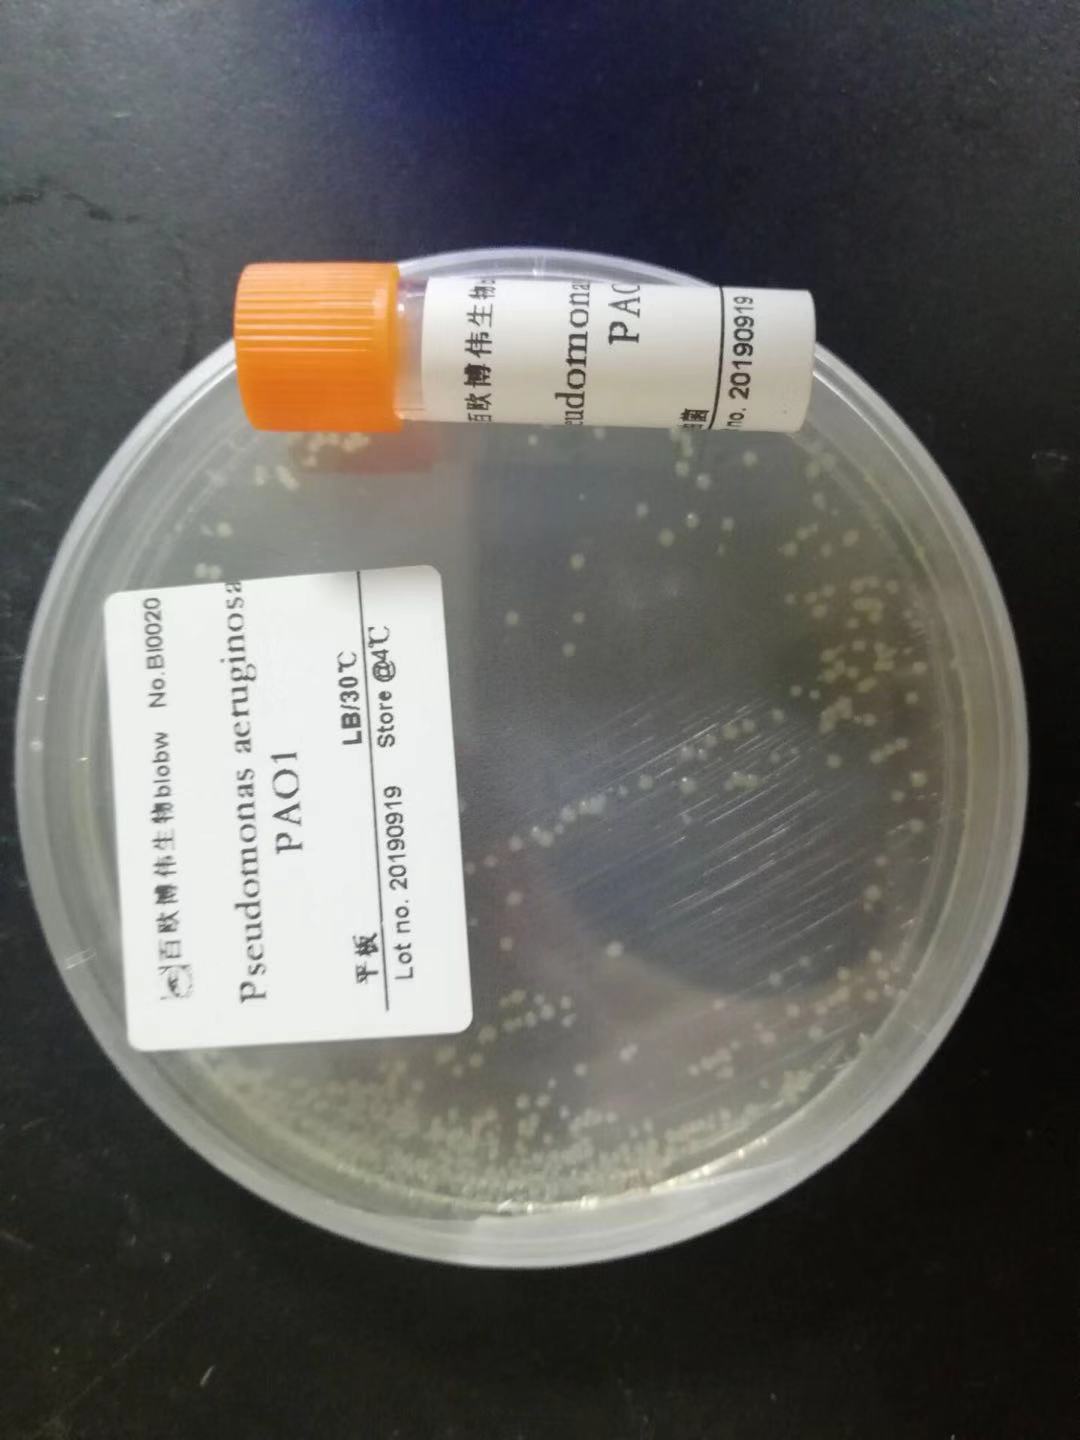
banner
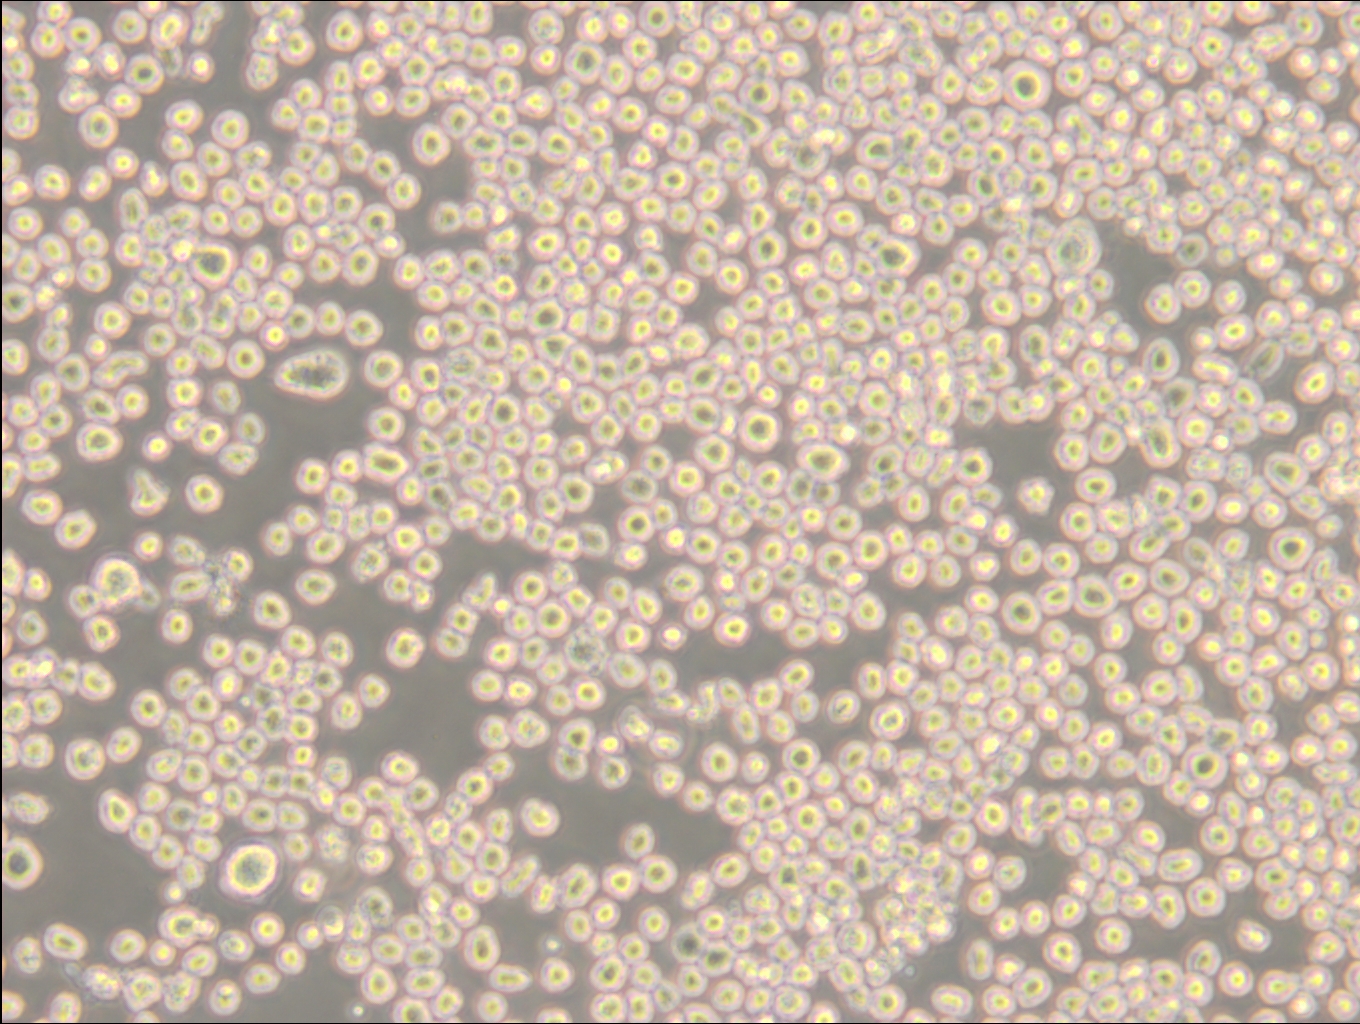
about banner

北京百欧博伟生物技术有限公司
北京百欧博伟生物技术有限公司
3 年
手机商铺
商家活跃:
产品热度:
- NaN
- 0.10000000000000009
- 0.10000000000000009
- 2.1
- 2.1
精品推荐0
- 中国微生物菌种
- 美国ATCC菌种
- 细胞系
- 培养基
- 原代细胞
- 质粒,质粒菌种
该分类产品即将上线哦~
关于我们查看全部

北京百欧博伟生物技术有限公司
北京百欧博伟生物技术有限公司拥有Biolog微生物鉴定系统,超低温冰箱,生物安全柜等仪器设备可进行对微生物分离、鉴定等常规的分子实验研究。对我国生命科学研究、生物技术创新和产业发展的需求进行积极的面对社会乃至国外收集保藏提供微生物菌种资源。在保证生物安全和保护知识产权的前提下,为工农业生产、卫生健康、环境保护、科研教育提供微生物物种资源、基因资源、信息资源和专业技术服务。 除此之外,我们还拥有对菌种、细胞、培养基、配套试剂等产品需求者的极优质服务,对购买项目的前期资料提供,中期合同保证,后期货物跟踪到最终售后的确保项目准确到位,都有相关人士进行维护,确保您在中国微生物菌种查询网中获得最优质服务!也正因为此,北京百欧博伟生物技术有限公司与国内外多家研制单位、生物制药、第三方检测机构和科研院所院校、化工企业有着良好、长期和稳定的合作关系! 为更好服务社会,创造双方利益最大化,我们特设了总共微生物菌种查询网(www.biobw.org)!专业为各企事业单位,科研